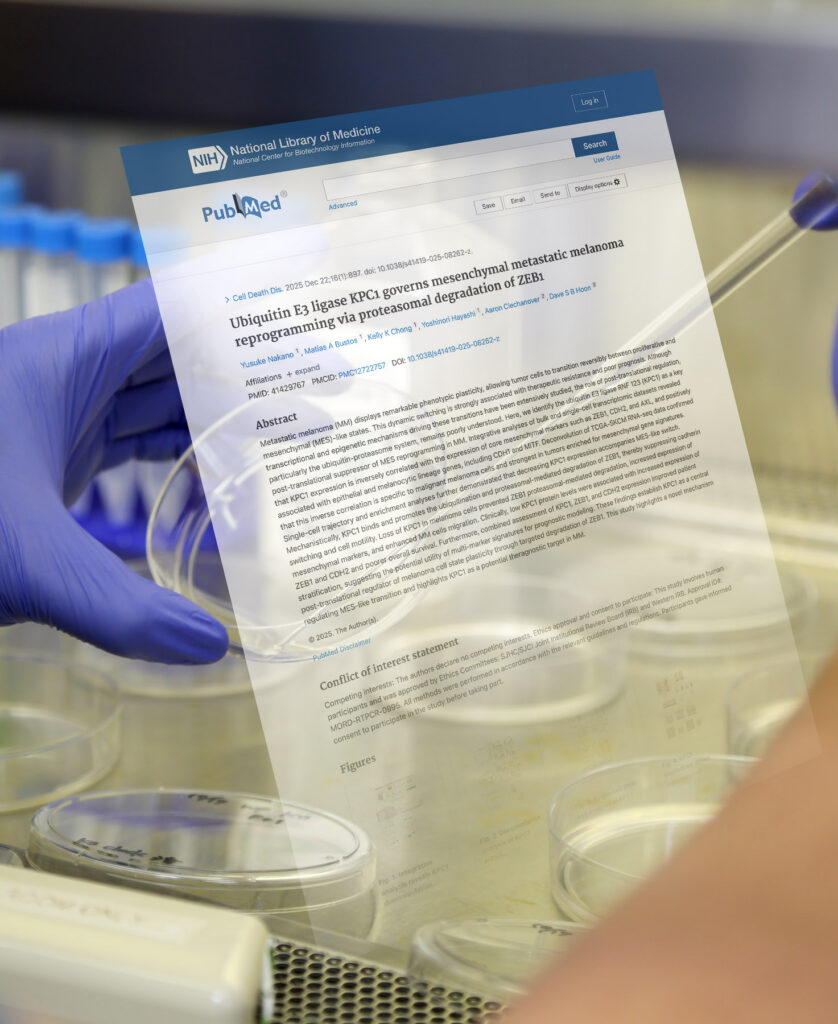
Translational Molecular Research Articles

Our Mission and Vision
The mission of the Translational Molecular Medicine Research department is the development of new approaches for the molecular diagnosis of metastasis with a strong emphasis on the identification of molecular biomarkers (genomic, epigenomic, transcriptomic) in blood , urine, and tissue that can be used in early-diagnosis, prognosis, drug resistance, and theragnostic targets. Our mission and goal are devoted to clinical translational research, collaborating with physicians and other scientists to improve cancer patient healthcare and clinical outcomes. Our recent main focus involves understanding DDR, senescent, and molecular immune responses.
Our vision is the employment of blood molecular biomarkers such as cell-free nucleic acid (cfNA; cfDNA, cfmiRNA) and circulating tumor cells (CTC) to aid in the management of cancer patients, early diagnosis, and evaluate modern therapeutics. In addition, we aim to fully understand ubiquitin and ubiquitins as they relate to tumor regulatory pathways and translational responses to therapy resistance.
Research Topics
We are highly focused on developing quantitative translational regulators of proteins role in solid tumors. Discoveries made in molecular studies and proteomics progression are rapidly translated for application at the bedside. We have partnered with biotech and pharmaceutical companies in developing treatment protocols and new molecular oncology approaches, the results of which may increase overall survival and eventually expedite development of a cure for patients with solid tumor cancers.
Main Projects

- We are assessing for molecular blood biopsies in blood and urine that include cell-free nucleic acids (cfNAs) (DNA, miRNA) and CTCs and exosomes. We assess/determine their clinical utility especially in diagnosis and prognosis during follow up of treatment.
- We assess cfNA and exosomes in patients who receive immune checkpoint inhibitor therapies.
- We identify various forms of epigenetic changes (methylation and histone) as related to metastasis and therapy resistance.
- Our dept. assesses DNA Damage Resistance (DDR) solid tumors.
- We examine primary and extracranial brain tumor cFNA and molecular biology for progression-related genes.
- Our Dept has focused on proteomics as related to activity during tumor progression and DDR, specifically regulatory mechanisms of specific ubiquilin and ubiquitins.
- Our studies also focus on molecular immune responses during treatment using our new approaches of spatial biology and single cell sequencing.